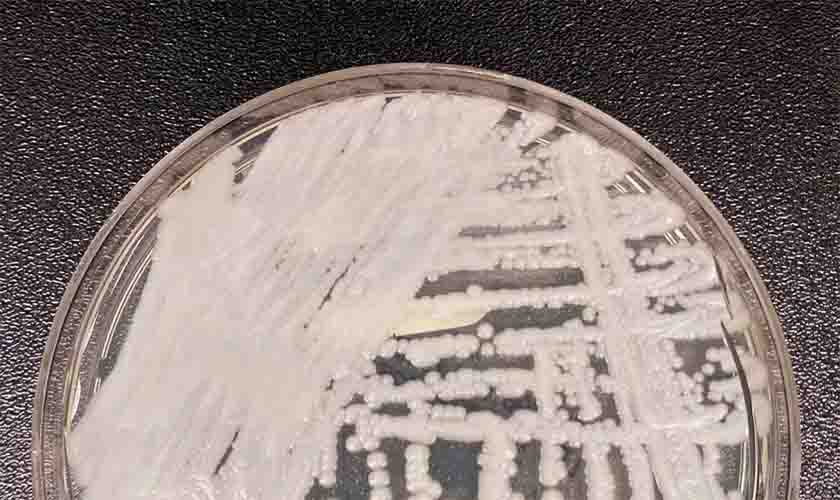
Anvisa confirma novo caso do superfungo Candida auris

Portaria permite regularização de empresas do Simples, com melhores condições de parcelamento
Sebrae apoia medida, mas espera que o Congresso Nacional derrube o veto ao Programa de Reescalonamento do Pagamento de Débitos no Âmbito do Simples Nacional (RELP)
A Procuradoria Geral da Fazenda Nacional (PGFN) publicou, nesta terça-feira (11), a Portaria 214/2022, que instituiu o Programa de Regularização Fiscal de Débitos do Simples Nacional inscritos em dívida ativa da União até 31/01/2022. Apesar dessa iniciativa, que melhora as condições para o parcelamento dos débitos inscritos na Dívida Ativa da União, o Sebrae defende que ainda é necessário que o Congresso Nacional derrube o veto presidencial dado ao Programa de Reescalonamento do Pagamento de Débitos no Âmbito do Simples Nacional (RELP).
“A nova portaria auxilia muito os pequenos negócios que estão com seus débitos já inscritos em Dívida Ativa da União, mas não resolve a situação dos débitos que ainda estão na Receita Federal, portanto é necessário que senadores e deputados derrubem, assim que os trabalhos forem retomados, o veto ao PLP 46/2021”, ressalta o presidente do Sebrae, Carlos Melles. "Historicamente, o Legislativo sempre apoiou os pequenos negócios, que mesmo na pandemia, foram responsáveis pela geração de mais de 2 milhões de empregos. Reconhecemos os avanços permitidos pelo governo, que foram fundamentais para atravessar esse período e contamos agora com o Congresso para dar o fôlego que as empresas precisam em prol da retomada da economia", frisou Melles.
O prazo para adesão ao novo Programa de Regularização Fiscal de Débitos do Simples Nacional, criado pela portaria 214/2022, termina no próximo dia 31 de março. O Programa permite ao MEI e à MPE optante do Simples Nacional, que foram afetadas pela pandemia, melhores condições de desconto e parcelamento, como entrada de 1% do valor total do débito, dividido em até oito meses. O restante pode ser parcelado em até 137 meses, sendo cada parcela determinada pelo maior valor entre 1% da receita bruta do mês imediatamente anterior e o valor correspondente à divisão do valor consolidado pela quantidade de prestações solicitadas.
A portaria ainda prevê desconto de até 100% de juros, das multas e dos encargos legais. Esse desconto deve observar o limite de 70% do valor total do débito. Os descontos são calculados a partir da capacidade de pagamento de cada empresa. A parcela mínima é de R$ 100,00 ou de R$ 25,00 no caso dos microempreendedores individuais. No caso de Transação do Contencioso de Pequeno Valor do Simples Nacional – débitos de até R$ 72.620 - o empresário que aderir ao edital pode escolher entre as diversas opções de pagamento com condições diferenciadas de parcelamento e desconto. Essa modalidade terá validade para débitos inscritos em dívida ativa até 31 de dezembro do ano passado.
O processo para negociar é 100% digital, no portal Regularize. Para saber como acessar pela primeira vez, clique aqui.
Saiba mais sobre as ações do Sebrae, acesse o site www.sebrae.ro ou ligue gratuitamente para 0800 570 0800. Você também pode acessar o Sebrae pelo WhatsApp pelo mesmo número. Siga o Sebrae em Rondônia nas redes sociais: Instagram, Facebook, Twitter, LinkedIn e YouTube (@sebraero).
Covid-19: Brasil tem 87,4 mil casos e 133 mortes em 24 horas
Número total de casos é de 22,7 milhões e 620,3 mil mortes
Saúde: boa parte dos sistemas de dados será normalizada até sexta
Anúncio acontece pouco mais de um mês após ataque hacker
Anvisa confirma novo caso do superfungo Candida auris
Identificado em 2020, organismo impõe ameaça à saúde, diz Anvisa

Comentários
Seja o primeiro a comentar
Envie Comentários utilizando sua conta do Facebook